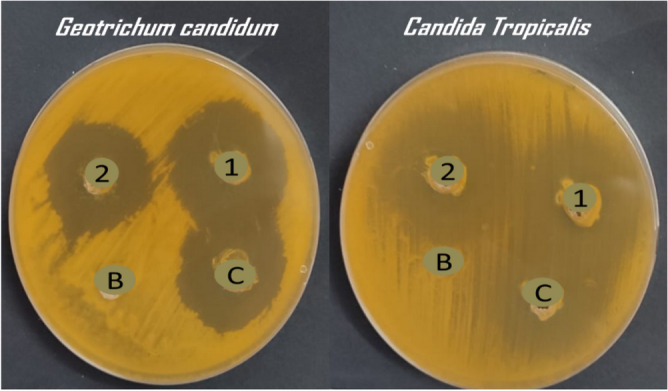
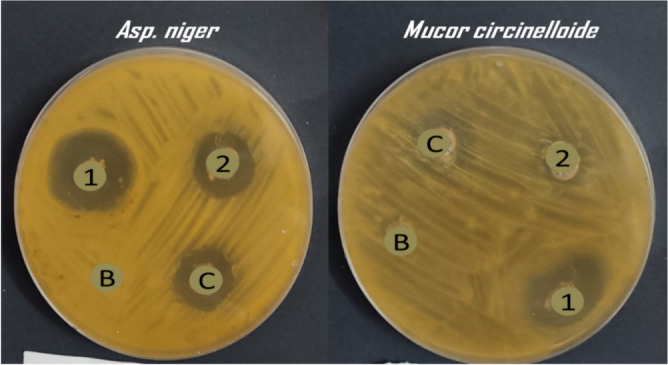
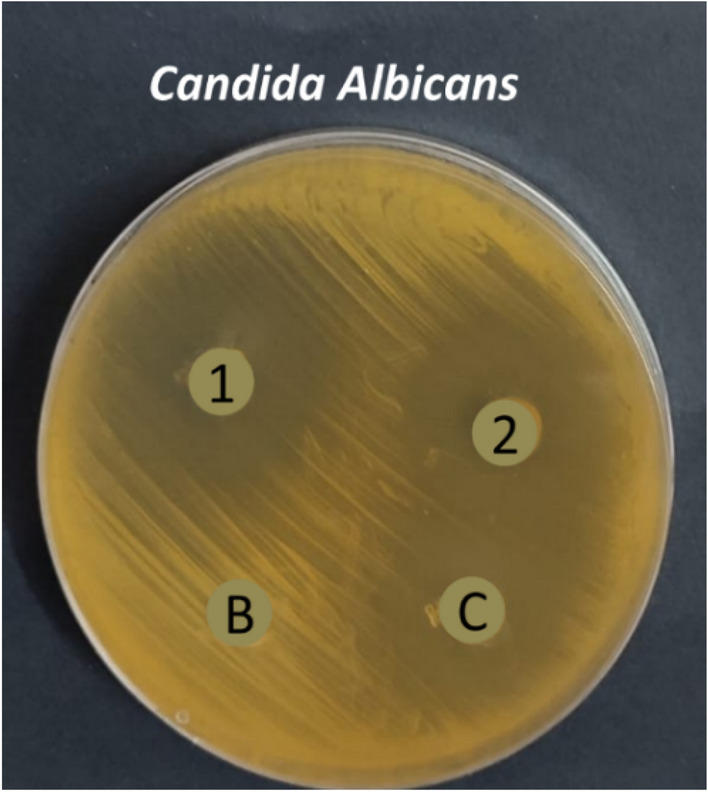

Abstract
Frequent and variant infections are caused by the virtue of opportunistic fungi pathogens. Candidiasis, aspergillosis, and mucormycosis are pathogenic microorganisms that give rise to vast fungal diseases that alternate between moderate to fatal in severity. The use of fluconazole as an antifungal drug was limited due to the acquired resistance in some types of Candida and other fungal species. This study aims to consolidate fluconazole’s biological effectiveness against several pathogenic fungi. Six active monoterpenes (MTs) of carvacrol, linalool, geraniol, α-terpinene, citronellal, and nerolidol were selected and encapsulated in nanostructure lipid carrier (NLC) with (NLC-Flu-MTs) and/without (NLC-MTs) fluconazole in one nanoformulation to determine if they will act synergistically or not? The synthesized nanoformulation NLC-Flu-MTs and NLC-MTs exhibited very good particle size of 144.5 nm and 138.6 nm for size and zeta potential values of (− 23.5 mV) and (− 20.3 mV), respectively. Transmission electron microscope investigation confirmed that the synthesized NLCs have regular and spherical shape. The abundance and concentration of the six released monoterpenes were determined, as a novel approach, using GC–MS with very good results and validity. In-vitro antifungal screening was done before and after nano co-delivery against seven pathogenic, and aggressive fungi of Candida tropicalis, Candida krusei, Candida glabrata, Geotrichum Candidum, Candidaalbicans, Aspergillus Niger, and mucor circinelloides. Inhibition Zone diameter (IZD) and the minimum inhibitory concentration (MIC) were measured. Nanoformulations NLC-Flu-MTs and NLC-MTs manifested potential and unique biological susceptibility against all the tested microorganisms with reduced (MIC) values, especially against Candida Tropicalis (MIC = 0.97 µg/ml) which represents 16-fold of the value shown by NLC-MTs (MIC = 15.6 µg/ml) and 64-fold of fluconazole free before nanoformulation (MIC = 62.5 µg/ml). The efficiency of nanomaterials, particularly NLC-Flu-MTs, has become evident in the diminishing value of MIC which affirmed the synergism between fluconazole and the other six monoterpenes.
Subject terms: Biochemistry, Biological techniques
Introduction
A fungus is one of the most diverse organisms in the world. Thus it’s essential to synthesize new fungicidal compounds with high selectivity for fungal receptors and low affinity for human receptors1,2. Recently, fungal infections have increased and are responsible for 1–2 million fatalities annually3. Aspergillus and Candida species are responsible for about 90% of deaths (∼ 90%), but other species like Candida tropicalis, Candida glabrata, Candida parapsilosis, Candida krusei, and Candida albicans enhanced rate of mortality (75%)4. Candida species have emerged as the most common cause of systemic fungal infections in hospitals worldwide. Although Candida albicans is the most frequently isolated yeast, non-albican Candida species including C. lipolytica, C. parapsilosis, and C. tropicalis are increasingly found5.
Azoles have a wide range of biological activities, including anticancer, anti-diabetic, anti-inflammatory and a variety of other medicinal purposes, especially as antimicrobial and antifungal agents6–10. Triazoles are an important class of azoles like 1,2,3-triazole derivatives, which in the last few years have been generated and evaluated for their antifungal activity, with some potential activity against various fungi. Effect of the nitrogen heteroatoms in the triazole ring system on the reactivity of lead compound target medication pharmacokinetics and metabolism are affected by the interactions of lead compounds with several target inhibitors11. Important approved triazole antifungals include fluconazole (Diflucan™), voriconazole (Vfend™) and posaconazole (Noxa-fil™), which appear to have expanded antifungal activity. Ketoconazole was the first drug used for oral systemic fungal infections. Subsequently, ongoing research attempted to design broad-spectrum antifungal agents, the triazole derivatives fluconazole and itraconazole were prepared and succeeded in achieving the purpose with an improved safety profile.
Fluconazole (Fig. 1) is one of the most recommended and prescribed antifungal agents for Candida infections. Like other triazole antifungals, fluconazole targets the ergosterol biosynthetic process in fungi, especially, Candida by inhibiting the cytochrome P450-dependent enzyme lanosterol 14-α-demethylase encoded by ERG11. Here, the free nitrogen atom in the triazole binds to the iron atom in the heme group of the enzyme12. As a result, oxygen is no longer activated, the demethylation of lanosterol is inhibited, and the ergosterol biosynthesis process is inhibited13. Since ergosterol is a substantial ingredient of the fungal cell membrane, this change is very detrimental to the accumulation of methylated sterols in the fungal cell membrane, and results in cell growth arrest14.
Figure 1.

The structure of fluconazole.
Fluconazole is fungistatic (drugs inhibit fungal growth) rather than fungicidal (drugs kill fungal pathogens). Today increase in fluconazole resistance is one of the crucial problems in long-term fungal infections. Resistance to fluconazole may result from different mechanisms, including the successive secretion of α-demethylase in ergosterol biosynthesis which mean ERG11 overexpression, which led to successive synthesis of Lanosterol 14α-demethylase that make the fluconazole need to be increased to compensate the excess of Lanosterol 14α-demethylase secreted (as the triazole in fluconazole ring binds to the heme group of the enzyme) made fluconazole less active and more resistant15–18 that typically associated with widespread and overuse of fluconazole as prophylaxis medications15. About 65% of fluconazole-resistant candida species mutations in the ERG11 gene expression19,20. Another factor contributing to fluconazole-resistant strains is the widespread involvement of secreted aspartyl proteinases (SAPs), which are considered potential factors affecting the virulence and extracellular proteolytic activity of the candida strains. SAPs also play an important role in colony formation, adhesion to the host cells via penetration, and tissue attack by destroying the surface, and cell membrane of the host cells21. A Family of SAP genes has been presented all of which were effective against the C. albicans pathogenicity22,23. Many trials have been made to get rid of fluconazole resistance and to restore its reactivity by converting fluconazole to its nanoform for example, fluconazole combined with curcumin and/or silver nanoparticle24 loading fluconazole on the surface of ZnO nps25, fluconazole conjugated with Cu–Ag and/ or ZnO nps26, fluconazole coupled with Au NPs27 and many other successive loading attempts using gel and lipid nps28,29.
Nystatin is one of the drugs combined with fluconazole and used for the treatment of recurrent vulvovaginal candidiasis (VVC) caused by C. albicans. Nystatin belongs to the polyenes family, which changes in the cell membrane permeability through binding to the sterols and causes the substantial contents of the fungus intracellular to be removed25. The utility of natural products (Terpenes) is one of the most attractive areas in medicinal and herbal chemistry. In one of the attempts to examine the antifungal efficacy of carvacrol, thymol, eugenol, and menthol terpenes as alternative agents to control fungus growth in the food industry, it was found that all the used Terpenes have a positive effect on all fungus strains with good minimal inhibitory concentrations ranged between 100 and 300 µg/ml and the activity order was thymol, carvacrol, eugenol and menthol30. Another study aimed to evaluate carvacrol and thymol as postharvest pathogens of Botrytis cinerea retardant, which causes stem and fruit rot during pre-harvesting. The results of this study indicated very strong antifungal activity, causing obvious changes in the morphology of the B. cinerea hyphae31. It has been reported that the using of carvacrol as an antifungal agent could be effective reasoning that due to, carvacrol could induce apoptosis in Candida albicans via different mechanisms of the total active and the mitochondrial reactive oxygen species (ROS) levels were exalted, and each of the mitochondrial transmembrane potential and morphology were changed. In addition, the cytosolic and mitochondrial calcium standards were also elevated32. Linalool is a very important member of monoterpenes, and has a major role as an antifungal agent, especially Candida albicans. The inhibitory effect of linalool against C. albicans's filamentous growth and biofilm formation was studied; the outcomes published attributed to the great effect of linalool on both fungal growth and biofilm formation. Additionally, gene expression estimated by RT-PCR confirmed the downregulation of HWP1 and ALS3. Like the adhesion genes (HWP1 and ALS3), the expression levels of long-term hyphae maintenance were also suppressed33 and some other studies confirmed that linalool is a very good antifungal agent34,35. The antifungal activity of geraniol and citronellol (alcoholic form of citronellal) was studied against the most common fungus causing dermatophytosis, trichophyton rubrum. One of the main outcomes of this study is, that the minimal inhibitory concentration is between 16 and 256 µg/ml for geraniol and 8–1024 µg/ml for citronellol against different strains of T. rubrum. In addition, using MIC and twice MIC could inhibit the mycelia growth and conidia germination, and fungal growth on nail fragments, and using half the MIC could cause wide, short, and crooked hyphae in T. rubrum morphology36. Not only do single citronellal or even citronellal have great antifungal but the citronella extracts enriched with both have also very good antifungal activities37. Peruvian piper is one of the most important plant extract enriched with natural terpenes like alpha terpinene and nerolidol, the antifungal study of this plant extract against the phytopathogenic Aspergillus niger, Botrytis cinerea, and Alternaria alternate revealed a very good activity those single compounds especially, with the fungus Botrytis cinerea38.
Frequent and variant infections caused by different fungal species in recent years. It poses a severe threat to humanity, especially people who undergo surgical interventions such as organ transplantation, which require taking immunosuppressants to make the body accept the transplanted organ. And those who suffer from autoimmune diseases, resulting in high incidence lethal rates39,40. Perhaps the Candida species, such as Candida albicans, tropicalis, glabrata, and krusei have the upper hand in causing most fungal infections. The real danger of these pathogens is not only the ease with which they spread but their acquisition of some resistance to antibiotics, not only azole antibiotics41–43 but also amphotericin B, especially the species C. albicans, C. glabrata and C. krusei44,45. The ability candida species, especially albicans, to infect such diverse hosts is confirmed by a wide range of virulence. A few hallmarks, including the morphological transformation from yeast to hyphal form, the expression of adhesion and invasions in the cell surface, biofilm formation, thigmotropism, response to contact stimulus, secretion of hydrolytic enzymes and phenotype switching in addition to the fast adaptation to the environmental pH-fluctuations46. Aspergillus niger, is a profiteer pathogen, usually presented in different indoor and outdoor environments47. It has special agility features such as spores can be easily aerosolized48, carried by air, and potentially can be deposited in bronchioles of the human respiratory system49 causing allergic bronchopulmonary aspergillosis which can be lethal in more susceptible patients50,51. Like what happens with different types of Candida, the Aspergillus niger has also recently shown resistance to some azole antibiotics, such as itraconazole and some triazoles52–55. Mucor circinelloides is depicted as one of the most frequent species of Mucorales which causes lethal mucormycosis. It was well known that Mucorales infections are difficult to treat easily, as a result of rapid propagation within the target host in addition to their low susceptibility to most of the antifungal agents and eventually drives to miserable scenarios than those made by aspergillosis56–58.
In connection to these findings of potential antifungal activity of carvacrol, linalool, citronellal, nerolidol, geraniol, and α-terpinene, what will happen if all those terpenes are mixed in definite concentration in one nanoformulation? Are they will affect fungal strains synergistically or anti-synergistically? If this is effective in treatment of fungal infections largely, how to measure the content of the drug loaded or released knowing that, all the chosen terpenes are comparable in their physical properties (liquids, low melting point)? Our passion for knowledge and in continuation of our interest in both synthesis and drug delivery applications59–70. We report herein the design of pre-selected, multi-component monoterpenes (Fig. 2) encapsulated into nanostructured lipid carrier (NLC) to test their antifungal activities against five pathogenic fungal strains, trying to determine what if the fluconazole and the pre-selected MTs work synergistically or not and to introduce a novel reliable chromatography approach to estimate the concentration of the drug-loaded and drug released.
Figure 2.

The structure of the selected Monoterpene to be encapsulated into nanostructured lipid carrier (NLC).
Materials and methods
Materials
Lauric acid 98%, oleic acid 99%, sodium glycocholate 97%, sodium tourocholate 97%, tween 20 98%, decarbonated water supplied from Sigma Alderich-Germany. Mono Terpenes, geraniol 99%, carvacrol 98%, linalool 97%, nerolidol 97%, α-terpinene 90%, citronellal 93% and n-hexane (HPLC-grad) were purchased from ACROS ORGANICS-Germany. Fluconazole powder was supplied as a gift from Amoun Pharmaceuticals Company, Obour city, Cairo, Egypt. All the chemical solvents and reagents were used without any purification or distillation. Monoterpenes (MT) selected to be encapsulated according to their miscibility in normal hexane and/or dichloromethane where all the selected MT completely miscible in n-hexane.
Preparation of nanostructured lipid carrier loaded with natural terpenes (NLC-MTs)
Nanostructured lipid carrier’s nanoformulation were synthesized according to hot homogenization method71. with little modifications, using a 50 ml beaker (B1, aqueous phase) 2.5 ml of tween 20 was added to a well stirred and filtered mixture of 0.01 g sodium glycocholate and 0.01 g sodium taurocholate dissolved in 10 ml distilled water. Using a pre-adjusted low-temperature water bath, the beaker (B1) was placed at a hotplate stirrer and shaken for a few minutes while the solution temperature was raised to 45 °C and kept warm to that temperature.
Parallel, solid and liquid lipids were mixed in a ratio of (1:2) and exactly, 500 mg (0.5 g) of lauric acid and 1000 mg (1 g) oleic acid were placed in a 50 ml beaker (B2 lipid part). Using a micropipette and 4-digit balance, weigh exactly 25 mg of each single natural terpenes geraniol, carvacrol, citronellal, α-terpinene, linalool, and nerolidol. The weighted amounts were injected separately, using a micropipette, in the middle of the oleic acid liquid lipid phase layer (all chosen MTs are completely miscible with oleic acid) to avoid the decomposition or volatilizing of natural terpenes as possible, then the mixture was placed at the water bath with the same conditions (low temperature) until all lauric acid converted from solid to its liquid phase (m.p 43.2 °C) and all solution became homogenous molten.
On hot (45 °C), the solution (B2) was added rapidly to the solution (B1) and kept heating for two minutes with a short lifetime (1 min) application of high shearing homogenization, and clear microemulsion was obtained. Attain the final solution to cool with stirring for two minutes then 10 ml of ice-cold water was added with sonication using a probe sonicator (200w for 7 min) keeping the solution cold till sonication finished. Then the final concentration was completed to 40 ml solution by adding distilled water and kept in a 50 ml falcon tube with a total concentration of 150 mg/40 ml. Using cry-protectant sugar, like trehalose or sucrose, the microdispersion converted from liquid to semi-solid substance by freeze-drying lyophilization for 2 days at -50 °C and kept at a temperature below 10 °C.
For fluconazole encapsulation, the same protocol was applied with the addition of 150 mg of fluconazole dissolved in distilled water, and complete solubility was achieved by heating or sonication. The fluconazole solution was added to the aqueous phase and then the mixture was warmed up using a water bath and the protocol was completed as mentioned earlier. The nanoformulation containing fluconazole and six essential oils was labeled as NlC-Flu-MTs whereas, the sample without fluconazole was labeled as NlC-MTs.
Particle size and surface charge
One of the most important measurements that control the quality of prepared nanoparticles is the hydrodynamic radius and polydispersity index (PDI) which is inspected using dynamic light scattering (DLS) at an angle of 173° in the room temperature. As DLS and PDI, zeta potential supports us with valuable data about nanoparticle's stability. Zeta potential (z.p) was investigated by measuring the frequent shift of the scattered light due to the particle charge at a scattering angle of 12°. Each of the radius, PDI, and Z.p were quantified with (Zeta Sizer Nano Series (HT), Nano ZS, Malvern Instruments, UK) in the Egyptian Petroleum Research Institute (EPRI). 5–10 mg of each liquid nanoformulation was dispersed and sonicated (sonication bath) in 10 mL of distilled, and then the sample was placed in quartz cell for analysis. For DLS and PDI, three measurements were analyzed and the best one was chosen.
Surface morphology by transmission electron microscope (TEM)
Transmission Electron Microscope described the internal morphology of NLCs nanoparticles to confirm the regularity of the nanoparticles and consequently shows the aggregations as one of the crucial aspects of nanoparticle stability. High-Resolution Transmission electron microscopy was used (HR-TEM, JSM-7100F) in the Egyptian Petroleum Research Institute (EPRI), Cairo; images were recorded with JEOL JEM-2100-115 high-resolution transmission electron microscopes with accelerating voltage 200 kV. Nearly, 1 µL of the NLCs nanoparticles was diluted with double distilled (1:200) and placed on a 200-mesh carbon-coated grid, and left for 2 min. The excess liquid was removed by cellulose filter paper. Two drops of 2% (w/w) phosphotungastic acid (PTA) were added to the carbon-coated grid for a short time of 10 s. to get hold of negative staining and the excess PTA was adsorbed via filter paper as earlier. Then the grid was fixed on the sample holder and the TEM was adjusted for imaging.
Monoterpenes abundance, drug release and concentration quantization using gas chromatography–mass spectrometry analysis (GC–MS)
Standard preparation
Exactly 10 µl of known concentration of each standard carvacrol, linalool, geraniol, α-terpinene, citronellal and nerolidol are mixed to obtain total volume of 60 µl which is completed to one ml by adding 940 µl of n-hexane or dichloromethane (HPLC grade), 10 µl of the mixture was injected to the GC–MS system (Agilent Technologies). After the GC–MS run is completed, the six monoterpenes are identified based on their mass fragmentation and the peak area will be specific for the standard concentration prepared.
Sample preparation
As the standard, the sample preparation was done with the same sequence, 10 µl of the sample was completed to 1 ml by adding 940 µl of n-hexane or dichloromethane to keep the dilution fixed in all preparations. The sample may be media from the drug released or free unloaded monoterpenes from centrifugation ultrafiltration which is done to estimate the encapsulation efficiency. 10 µl was taken from the sample mixture and injected to the GC–MS system (Agilent Technologies). After the GC–MS run is completed, the six monoterpenes are separated and identified based on their mass fragmentation and in this case the peak area will be specific for the sample concentration prepared.
Drug (monoterpenes) release
To determine the released (in-vitro) monoterpene’s abundance and concentration from the synthesized NLC nano-capsule, a dialysis bag protocol was accomplished72,73. About 10 cm of dialysis bag was soaked in distilled water for 12 h prior conducting the release study protocol. Nearly 10 ml of NLC-MTs nanoformulation was poured into a dialysis bag (MWCO 12 kDa, Sigma Aldrich) tied at two ends to keep the nanoformulation inside. The dialysis bag was fully immersed in a 250 ml beaker containing 100 ml of distilled water mixed with 2 ml tween 20 which was placed in an incubator at a temperature of 25 °C with occasional stirring from time to time. The solution was taken out and 10 ml of the release media was withdrawn at different time intervals of 0–72 h (batches) whereas, another 10 ml of fresh distilled water was added to compensate for what was lacking. The withdrawn volume of release media containing monoterpenes active ingredients (MTs) released in case of NLC-MTs nanoformulation, and each of MTs and fluconazole in case of NLC-Flu-MTs nanoformulation were directly, mixed with10ml of n-hexane as organic phase to extract all MTs and fluconazole (soluble in n-hexane)74. The extraction step was repeated several times, keeping the dilution factor in account. Solvent extraction was preceded using a proper separatory funnel and this step was repeated three times for the same batch to confirm the complete extraction of natural terpenes then all organic layer of n-hexane was collected (for the same batch) and dried using anhydrous magnesium sulfate. Before injection to GC mass, the extracts were concentrated under vacuum to a definite concentration then the sample was injected to GC to evaluate the abundance and concentration regarding the dilution (Fig. 3). The abundance of MTs was identified according to their mass fragmentation and the peak area will be specific for the sample concentration which could be calculated from the Eq. (1).
| 1 |
Figure 3.
Schematic illustration of the concentration-determination of the six terpenes encapsulated NLC nanoparticles for drug release and encapsulation efficiency.
Entrapment efficiency
The encapsulation efficiency (E.E) of the prepared NLCs was determined according to centrifugation ultrafiltration method75. Using Vivaspin 20 centrifugal concentrator tube. Aliquots of freshly prepared NLC samples (10 ml) were placed on the ultrafiltration tube supported with polyethersulfone membrane (PES) with a 50kDa cut-off (Sigma Aldrich, Germany). After centrifugation (10,000 rpm, 10 min) with Heal Force@ (Neofuge 15R refrigerated centrifuge, China), the non-encapsulated (Free) monoterpenes was filtered and mixed with the aqueous media filtration. Like the drug release study, free monoterpenes was collected by adding n-hexane several times by solvent extraction to emphasize complete drug extraction. Hexane-containing free terpenes were collected and dried by passing through anhydrous magnesium sulfate, followed by re-concentration under vacuum to a specific volume keeping the dilution factor into account then the sample was injected into the GC–MS to determine the abundance and concentration of the free non-encapsulated monoterpenes (Fig. 1). The entrapment efficiency is then calculated from Eq. (2).
| 2 |
GC–MS analysis
GC–MS system (Agilent Technologies) was equipped with a gas chromatograph (7890B) and mass spectrometer detector (5977A) at Central Laboratories Network, National Research Centre, and Cairo, Egypt. Samples were diluted with hexane (1:19, v/v). The GC was equipped with a DB-624 column (30 m × 320 μm internal diameter and 1.8 μm film thickness). Analyses were carried out using helium as the carrier gas at a flow rate of 3.0 ml/min at a split 1:20 of, injection volume of 1 µl and the following temperature program: 40 °C for 1 min; rising at 7 °C/min to 250 °C and held for 5 min. The injector and detector were held at 250 °C. Mass spectra were obtained by electron ionization (EI) at 70 eV; using a spectral range of 30–440 m/z and solvent delay of 6 min. Identification of different constituents was determined by comparing the spectrum fragmentation pattern with those stored in Wiley and NIST Mass Spectral Library data. Semi-quantitative data were obtained from GC–MS area percentages, the retention time and peak area for each single natural terpene were used to calculate the concentration. Peak identification was performed by comparing the relative retention time of each compound with those of standard materials.
Biology evaluation
In-vitro antimicrobial screening (inhibition zone)
The Clinical and laboratory standards institute (CLISI) recommended the most popular technique for estimating antimicrobial susceptibility testing as the well diffusion method. One of the main potential usefulness of this disk diffusion method is that results could be obtained after a relatively short time as an inhibition zone diameter in mm within 16–48 h of the incubation that is shorter incubation time than the method described by the M38. The tested fungus strains of candida albicans (ATCC-10221), Candida Tropicalis (ATCC-131803), Candida krusei (ATCC-14243), Candida glabrata (ATCC-15126), Geotrichom candidum (ATCC-34614), Aspergillus niger (KU681408) and Mucor citcinelloid (ATCC-8542) were ± and the inculcation preparation was done using direct colony suspension as follows; the inoculum was prepared by making a direct broth or saline suspension of the isolated colonies within 24 h in an agar plate using the non-selective medium, such as blood agar. The suspension adjusted to achieve turbidity equivalent to 0.5 McFarland standard which leads to approximately 1 × 108 CFU/ml by using either visual or spectrophotometric method. The antimicrobial assessment using the well diffusion method is usually used to assess synthetic compounds as well as plant extracts, whereas the agar plate surface was inoculated by wiping the target microbial inoculum over the whole agar surface. Holes with a diameter of 6–8 mm were punched aseptically with a sterile cork borer or a tip, and a volume (20–100 µl) of specific concentration (10 mg/ml dissolved in 0.9% saline or DMSO) of the antimicrobial agent under investigation after dissolution in a specific solvent (have no antimicrobial properties) was introduced into the well. The plates were incubated under suitable conditions depending on the tested microorganism at a temperature of 35 ± 2 °C in an ambient air incubator within 15 min of adding the inoculum. To maintain the same incubation temperature for all cultures, do not stack micro-dilution trays more than four high. To prevent drying, seal each tray in a plastic bag, with plastic tape, or with a tight-fitting plastic cover before incubating. After incubation time has passed (24 h is recommended in the case of Aspergillus niger, Mucor citcinelloid, Candida tropicalis, Candida albicans, Candida krusei, Candida glabrata and Geotrichum candidum depending on the nature of the microorganism. From its name, the antimicrobial agent diffuses through the agar medium and causes growth inhibition76,77. The resulting inhibition zone diameters surrounding the wells should be measured to the nearest whole millimeter at the point at which there is a prominent reduction in growth. If growth is insufficient at the recommended times, the plates should be re-incubated and read later.
Determination of minimum inhibitory concentration
Minimum inhibitory concentration (MIC) shows the minimum or lowest concentration of an antimicrobial agent that prevents the visible growth of a microorganism in broth dilution susceptibility test. The sample (10 mg) was dissolved in 10 ml distilled water to prepare the concentration of 1000 µg/ml as a stock solution. Based on the broth micro dilution method78, two-fold dilutions of antimicrobial agent in a broth were prepared (1000, 500, 250, 125, 62.5, 31.25, 15.6, 7.8, 3.9, 1.95 and 0.97 μg/ml) were prepared. The inoculum was prepared by taking a few colonies from the agar plate with a sterile swap to prepare McFarland standard which diluted with the media. Dispense the antimicrobial/broth solutions into the 96 plastic microdilution trays and incubation processed. Turbidity indicates growth of the microorganism, and the MIC is the lowest concentration where no growth is visually observed.
Results and discussion:
Particle size and distribution
To identify at which range of size the sample was prepared, DLS was done and the particle size exposed 144.5 and 138.6 nm for NLC-Flu-MTs and NLC-MTs, respectively as shown in Figs. 4 and 6. The particle size of the nanostructured lipid carrier encapsulated with monoterpenes active ingredients only revealed a smaller size which may confirm that increasing the number of loading components affected the particle size and made the droplet size larger. In addition to DLS, the particle homogeneity size distribution or polydispersity index, (PDI) is a crucial factor promoting stability. Smaller values of pdi, from 0.0 to 0.3, point out to more homogenous particles and very narrow size distribution, and the particles near to be monodispersed but when the value of pdi > 0.3, the particles will act as poly dispersed79. The values of pdi presented by NLC-Flu-MTs and NLC-MTs were 0.121 and 0.066, respectively which means the addition of fluconazole as an extra component makes severe changes in the physiochemical properties of the particle distribution, via making size-varied particles and that breaks the homogeneity to some extent and makes the pdi value in case of NLC-Flu-MTs became larger.
Figure 4.
Size distribution and polydispearsity index of (NLC-FLu-MTs).
Figure 6.
Size distribution and polydispearsity index of (NLC-AI).
Flu-MTs but both nanoformulation even with or without fluconazole still homogenous solution that as presented in Figs. 4 and 6.
Zeta potential is one of the extremely important physical stability parameters, as increasing the charge, even if negative or positive, indicates a more stable colloidal system. The nanoformulation of NLC-Flu-MTs showed z.p value of − 23.5 mV whereas, NLC-MTs presented − 20.3 mV. The values of z.p presented in Figs. 5 and 7 confirmed that the two nanoformulations showed good physical stability as we move away from the zero-charge point (positive or negative) which encourages better stability. The reason for high stability is due to high repulsive forces between the same charges that make the chances of aggregation diminished (Figs. 6, 7).
Figure 5.
Zeta potential of (NLC-Flu-MTs).
Figure 7.
Zeta potential of (NLC-FLU-MTs).
NLC surface morphology by transmission electron microscope (TEM)
For a high-resolution view of the internal morphology, a transmission electron microscope was used to show the shape of the nanoparticles prepared. The field shown in Fig. 8a approved that the prepared NLC-MTs have regular and spherical shapes in a range of size 90 up to 100 nm. The particle became larger, and the morphology changed a little bit to be a spherical, semispherical, and oval shape. The encapsulation process is shown in Fig. 8b the results from DLS and z.p confirmed the same consequences of size and homogeneity, also TEM showed no aggregation at most of the field imaged and that is inconsistent with the values of PDI, especially in case NLC-MTs. The internal dark area shown in Fig. 8b represented the encapsulated active ingredients in the vicinity of NLC meanwhile, the gray outer layer represented the phospholipid and surfactant layer.
Figure 8.
Internal structure and morphology by transmission electron microscope.
Encapsulation efficiency, in-vitro monoterpenes release and their concentration quantization by GC–MS
The use of a nanocarrier is a breakthrough tool that helps us to reach sites it was previously difficult to access and the quantity in addition to concentration of the drug released (one component) could be estimated easily via a different protocol like dialysis bag, Franz-type diffusion cells80 and consequently the drug loading capacity calculated smoothly. Based on different literatures on natural active ingredients, herein we designed a tailored nanoformulation consisting of multiple effective antifungal drugs of six mono terpenes co-delivered with fluconazole. The synthesized nanoparticles tested for their antifungal activity, and promising results were obtained especially, NLC-Flu-MTs. The potential effect of nanoformulation is due to the synergistic effect of all components together.
There was a mandatory need to know the quantity of the actual drug loaded, the main problem here was all mono terpenes have comparable physical properties and light absorbability. The choices are limited, and each method has its drawbacks, the concentration determination could be carried out using spectrophotometry such technique, that is very reliable and was used widely to determine the concentration61,81 via making a standard curve, and the concentration is calculated directly by comparison. The encapsulation of six monoterpenes at the same nanoformulation makes the concentration determination using UV spectrophotometry may be not accurate due to the comparable ƴmax for each one of the monoterpenes used in this study that makes the measurements interferential.
Gas chromatography–mass spectrometry (GC–MS) is one of the most reliable tools to estimate the concentration of volatile components like an essential oil in a mixture82 and the concentration determination step requires a known concentration of the standard to be injected and consequently, the separation parameters of the area percentage, retention time and peak area for each component obtained which is very specific to the standard itself. Knowing the sample and standard separation parameters, the concentration determination is no longer difficult and has become accessible. After the standards (mixture) injection, the chromatogram (Fig. 9) showed seven peaks instead of six peaks, the reason for the extra peak comes from the existence of two isomers of nerolidol which appeared at two different retention times of 24.438 and 24.972 (min) for the isomers Z-nerolidol and E-nerolidol, respectively in addition to six single peaks at retention times of 21.03, 19.30, 17.01, 15.80 and 13.26 min (Table 1). Based on the fragmentation pattern and mass spectra, the identification of every single monoterpene was accomplished by comparing the spectrum fragmentation pattern with those stored in Wiley and NIST Mass Spectral Library data. The basic, six retention times were best fit for monoterpenes: carvacrol, geraniol citronellal, linalool, and α-terpinene, respectively, the corresponding standards peak area related to concentration and detected peak area of monoterpenes with related concentration after two hours drug release listed in Table 3. Generally, the synthesized NLCs exhibited very good encapsulation efficiency (Table 5) ranging from 84 up to 98%. The encapsulation efficiency was determined by estimating the unloaded or free non-encapsulated MTs using ultrafiltration certification, such tool permits the free MTs to be separated from NLC loaded, the free MTs identified and concentration determined in the same manner discussed before, and consequently the loaded MTs by contrary way using Eqs. (1) and (2). For the MTs drug release study, the samples taken from the release media at time intervals 0 (before release, at the beginning) up to 72 h were processed and identified as the same as standards. Similarly, the same seven peaks were obtained, confirming that all encapsulated monoterpenes released successfully including the presence of the same isomers Z-nerolidol and E-nerolidol. The integration peak list (Table 2) at the first two hours (Fig. 10), for instance, is used to calculate the exact concentration of each monoterpene released via Eq. (1), thus the total monoterpene e.g., carvacrol, released over 72 h equals the summation of microgram released from time zero to 72 h via Eq. (3). Despite the non-aqueous nature of the loaded oils, they will be liberated effectively in a short period in the release media and according to Table 4 and Fig. 11 it was found that the carvacrol release curve (purple) and citronellal release curve (red curve) have generous drug release where they exonerated more than 67% (16.5 mg) of its original (25 mg) concentration through the first 72 h, regarding to their entrapment efficiency 97.8% and 94.9%, respectively which could be calculated by Eq. (4). It’s noteworthy that the order of drug release capabilities ascendingly from the lowest to the highest one as α-terpinene, geraniol, nerolidol, linalool, citronellal and carvacrol, respectively (Tables 1, 2, 3, 4, 5).
| 3 |
| 4 |
Figure 9.
Chromatogram of the standards mixture.
Table 1.
Integration peak list of standards mixture.
| Peak | Start | RT | End | Height | Area | Area % |
|---|---|---|---|---|---|---|
| 1 | 13.173 | 13.262 | 13.339 | 406,678.88 | 1,541,316.38 | 74.17 |
| 2 | 15.707 | 15.808 | 15.889 | 369,513.3 | 1,497,195.3 | 72.04 |
| 3 | 16.918 | 17.013 | 17.11 | 355,431.53 | 1,359,477.83 | 65.42 |
| 4 | 19.194 | 19.304 | 19.488 | 344,003.85 | 1,436,341.25 | 69.11 |
| 5 | 20.936 | 21.031 | 21.322 | 418,592.55 | 2,078,204.8 | 100 |
| 6 | 24.349 | 24.438 | 24.515 | 306,904.98 | 1,077,254.34 | 51.84 |
| 7 | 24.879 | 24.972 | 25.061 | 363,567.01 | 1,372,377.83 | 66.04 |
Table 3.
Injected standards monoterpenes peak area and related concentration.
| Compound | Area | Conc. (µg/ml) |
|---|---|---|
| STD (standards) | ||
| α-Terpinene | 1,541,316.4 | 7.533 |
| Linalool | 1,497,195.3 | 8.3517 |
| Citronellal | 1,359,477.8 | 7.998 |
| Geraniol | 1,436,341.3 | 8.692 |
| Carvacrol | 2,078,204.8 | 9.272 |
| Nerolidol | 2,449,632.2 | 8.439 |
| Drug release sample 1 (DRS-1) | ||
| α-Terpinene | 195,193.74 | 95.40 |
| Linalool | 213,206.8 | 118.93 |
| Citronellal | 324,678.91 | 191.01 |
| Geraniol | 158,403.54 | 95.86 |
| Carvacrol | 414,874.08 | 185.10 |
| Nerolidol | 319,676.73 | 110.13 |
Detected peak area of monoterpenes and related concentration after 2 h drug release.
Table 5.
Free unloaded MTs peak area, concentration, and encapsulation efficiency.
| Free unloaded MTs | Loaded MTs = total added-free drug (µg/ml) | EE (%) = (Loaded MTS/total drug added) × 100 | |||
|---|---|---|---|---|---|
| Compound | Area | Conc. (µg/ml) | (Dilution factor) Conc. × 10 (µg/ml) unloaded MTs | ||
| α-Terpinene | 336,845.03 | 164.63 | 1646.28 | 23,353.71009 | 93.415 |
| Linalool | 240,331.13 | 134.06 | 1340.6 | 23,659.37764 | 94.638 |
| Citronellal | 216,087.01 | 127.13 | 1271.27 | 23,728.72961 | 94.915 |
| Geraniol | 153,981.21 | 93.18 | 931.8 | 24,068.18475 | 96.273 |
| Carvacrol | 119,301.11 | 53.23 | 532.2 | 24,467.73297 | 97.871 |
| Nerolidol | 1,121,231.44 | 386.27 | 3862.650172 | 21,137.34983 | 84.549 |
Table 2.
Integration Peak List of drug release sample after 2 h.
| Peak | Start | RT | End | Height | Area | Area % |
|---|---|---|---|---|---|---|
| 1 | 13.175 | 13.239 | 13.304 | 69,502.79 | 195,193.74 | 47.05 |
| 2 | 15.709 | 15.768 | 15.827 | 75,352.49 | 213,206.8 | 51.39 |
| 3 | 16.914 | 16.985 | 17.05 | 111,116.87 | 324,678.91 | 78.26 |
| 4 | 19.204 | 19.258 | 19.424 | 53,495.51 | 158,403.54 | 38.18 |
| 5 | 20.938 | 21.003 | 21.187 | 143,524.38 | 414,874.08 | 100 |
| 6 | 24.35 | 24.416 | 24.481 | 46,241.92 | 131,032.41 | 31.58 |
| 7 | 24.885 | 24.944 | 25.009 | 67,077.94 | 188,644.32 | 45.47 |
Figure 10.
Chromatogram of the drug release sample after 2 h.
Table 4.
Drug released (D.R) of MTs versus time and release percentage.
| Compound | Concentration of released MTS (µg/ml) | Total release µg/ml | Total release mg/ml | Entrapment efficiency (%) | Released percent (%) after 72 h | ||||||||
|---|---|---|---|---|---|---|---|---|---|---|---|---|---|
| 0 h | 2 h | 4 h | 6 h | 8 h | 10 h | 24 h | 48 h | 72 h | – | – | – | – | |
| α-Terpinene | 0 | 954 ± 55 | 663.7 ± 29 | 885.4 ± 58 | 763.3 ± 55 | 788.1 | 1248.4 | 1034 | 1331.1 | 8157.3 | 8.1573 | 93.4 | 34.935 |
| Linalool | 0 | 1189.3 | 1001.2 | 1343.6 | 1306.8 | 1276.5 | 2090.3 | 1711 | 1657.8 | 11,576.1 | 11.5761 | 94.6 | 48.948 |
| Citronellal | 0 | 1910.1 | 1541.8 | 2039.4 | 1897.6 | 1869.9 | 2083.9 | 2274 | 2380.1 | 15,996.7 | 15.9967 | 94.9 | 67.426 |
| Geraniol | 0 | 958.6 | 784.5 | 1120.4 | 1169 | 1131.4 | 2383.3 | 1239 | 1632.8 | 10,418.9 | 10.4189 | 96.2 | 43.322 |
| Carvacrol | 0 | 1851 | 1520.9 | 2081.2 | 2044.2 | 2015.6 | 2216.8 | 2466 | 2344.8 | 16,540.8 | 16.5408 | 97.8 | 67.652 |
| Nerolidol | 0 | 1101.3 | 912.4 | 1295.7 | 1321.5 | 1322 | 1325.3 | 1454 | 1234.7 | 9967.2 | 9.9672 | 84.5 | 47.182 |
Figure 11.
Drug release of the NLC-MTs active ingredients.
Antifungal activity
In-vitro antimicrobial screening (inhibition zone)
Herbal medicine is a very important class of medicinal chemistry and its therapeutical effect extended to include treatment of different diseases. The use of plant extracts as antifungal was proven in many studies in the last ten years and all researchers participating in these studies attributed the reason for the activity of these extracts to the fact that they contain natural compounds like monoterpenes, alkaloids, and others. From the literature, it was found that each of carvacrol, linalool, α-terpinene, citronellal, geraniol, and nerolidol has special antifungal properties. We designed herein, a combination of six monoterpenes in one nanostructured lipid carrier (2nd generation of lipid nanoparticles) nanoformulation and studied for its antifungal effect, to find out if they work synergistically or anti-synergistically when combined with fluconazole which almost lost its major activity due to resistance against different fungal strains. The two nanoformulation prepared consist of fluconazole in addition to a six monoterpenes encapsulated within the vicinity of NLC nanoparticles (NLC-FLu-MTs) and without fluconazole (NLC-MTs). The two nanoparticles are in-vitro tested against seven different fungus strains, C. albicans, C. tropicalis, C. krusei, C. glabrata, G. candidum, A. niger, and Mucor citcinelloid. Antimicrobial activity evaluated regarding the inhibition zone diameter and minimum inhibitory concentration presented in Tables 6 and 7. Individual monoterpenes showed modest antimicrobial activity against all the tested microorganisms. Nanoformulation with/without fluconazole depicted a noticeable and sharp change in its activity against most of the studied fungus strains.
Table 6.
Antifungal screening of the prepared NLCs (zone inhibition diameter).
| Fungus strain | Inhibition zone (mm) of each single component and tailored NLCs | ||||||||
|---|---|---|---|---|---|---|---|---|---|
| α-Terpinene | Carvacrol | Nerolidol | Citronellal | Geraniol | FLU | 1 (NLC-FLU-MTs) | 2 (NLC-MTs) | Cont | |
| C. tropicalis | 12 ± 0.41 | 18 ± 0.60 | 18 ± 0.42 | 18 ± 0.33 | 22 ± 0.62 | 21 ± 0.2 | 35 ± 0.75 | 27 ± 0.80 | 22 ± 0.4 |
| C. krusei | NA | 19 ± 0.20 | NA | 18 ± 0.30 | NA | 14 ± 0.10 | 27 ± 0.40 | 22 ± 0.20 | 13 ± 0.10 |
| C. glabrata | NA | NA | NA | 14 ± 0.10 | NA | 11 ± 0.08 | 30 ± 0.50 | 14 ± 0.28 | 15 ± 0.14 |
| G. candidum | 14 ± 0.11 | 24 ± 0.00 | 22 ± 0.18 | 24 ± 0.22 | 18 ± 0.15 | 20 ± 0.18 | 32 ± 0.45 | 30 ± 0.64 | 27 ± 0.33 |
| C. albicans | 18 ± 0.16 | 16 ± 0.10 | 18 ± 0.14 | 22 ± 0.19 | 24 ± 0.26 | 16 ± 0.17 | 33 ± 0.59 | 29 ± 0.49 | 24 ± 0.22 |
| Asp. niger | NA | 14 ± 0.12 | 22 ± 0.15 | 11 ± 0.07 | 19 ± 0.25 | 16 ± 0.19 | 26 ± 0.23 | 19 ± 0.20 | 18 ± 0.21 |
| Mucor circinelloide | 12 ± 0.09 | 15 ± 0.09 | 13 ± 0.10 | 14 ± 0.10 | 11 ± 0.10 | 14 ± 0.16 | 18 ± 0.19 | 11 ± 0.1 | 18 ± 0.19 |
Table 7.
Minimal inhibitory concentration of NLCs nanoformulations.
| Fungus strain | Minimal inhibitory conc. of each single component and tailored NLCs | ||||||||
|---|---|---|---|---|---|---|---|---|---|
| α-Terpinene | Carvacrol | Nerolidol | Citronellal | Geraniol | Flu | 1 (NLC-Flu-MTs) | 2 (NLC-MTs) | Cont | |
| C. tropicalis | 62.5 ± 2.33 | 62,5 ± 2.45 | 125 ± 8.29 | 31.2 ± 1.98 | 62.5 ± 2.93 | 62.5 ± 2.55 | 0.97 ± 0.09 | 15.6 ± 1.13 | 31.2 ± 2.34 |
| C. krusei | NA | 125 ± 7.51 | NA | 125 ± 8.33 | NA | 62.5 ± 3.14 | 31.2 ± 1.32 | 31.2 ± 1.67 | 125 ± 8.02 |
| C. glabrata | NA | NA | NA | 125 ± 8.44 | NA | NA | 31.2 ± 2.15 | 62.5 ± 1.95 | 125 ± 6.07 |
| G. candidum | 62.5 ± 3.11 | 125 ± 8.77 | 31.2 ± 1.37 | 31.2 ± 2.91 | 125 ± 8.34 | 125 ± 7.98 | 3.9 ± 0.69 | 7.8 ± 0.86 | 31.2 ± 2.17 |
| C. albicans | 31.2 | 31.2 | 250 | 62.5 | 62.5 | 125 | 1.9 ± 0.62 | 3.9 ± 0.99 | 31.2 ± 1.89 |
| Asp. niger | NA | 125 | 125 | 125 | 125 | NA | 15.6 ± 1.02 | 31.2 ± 1.87 | 62.5 ± 2.66 |
| Mucor circinelloide | 31.2 | 62.5 | 125 | 125 | NA | NA | 31.2 ± 1.13 | 62.5 ± 2.94 | 31.2 ± 2.19 |
Potential antimicrobial activity exhibited by the nanoformulations of NLC-Flu-MTs and NLC-MTs. The nanoformulation which contains fluconazole combined with monoterpenes active ingredients NLC-FLu-MTs presented broadened inhibition zones (i.z) of 35, 27, 30, 32, 33, 26, and 18 mm, meanwhile nanoformulation without fluconazole NLC-MTs, Which is not much different from the previous one depicted inhibition zones of 27, 22, 14, 30, 29, 19, and 11 mm against the fungus C. tropicalis, C. krusei, C. glabrata, G. candidum, C. albicans, A. niger and Mucor citcinelloid, respectively (Table 6). The represented inhibition zones shown in Figs. 12, 13, and 14 controversy settled in favor of fluconazole-based nanoformulation. The most affected fungi by the fluconazole-based NLC were C. tropicalis (35 mm) and G. candidum (33 mm) strains, especially NLC-FLu-MTs nanoformulation which have the best antifungal sustainability and reduced minimal inhibitory concentration. The minimal inhibitory concentration (MIC) is defined as the lowest concentration of the antimicrobial agent that inhibits the visible microbial growth. According to Table 7, the values of MIC progressed by NLC-Flu-MTs and NLC-MTs were very interesting and promising results exceptionally C. tropicalis 0.97 µg/ml and 15.6 µg/ml, respectively). This contrasts with the values given by individual components before the nano system co-delivery. Carvacrol, geraniol, citronellal, nerolidol, and α-terpinene, all of these terpenes showed a not-so-great effect on the tested microbes, while the synergistic effect of these compounds together in a single nanoformulation with and /without fluconazole led to an increase in their antimicrobial effect through suppressing its minimal inhibitory concentration 128 folds, for nerolidol (MIC = 125 µg/ml) against C. tropicalis, if compared to NLC-Flu-MTs (MIC = 0.97 µg/ml) and 16 folds if compared to NLC-MTs (15.6 µg/ml), against the same fungi, respectively. Although Monoterpenes encapsulated NLC without fluconazole showed very good MIC value, when compared to monoterpenes encapsulated NLC with fluconazole (NLC-Flu-MTs) the MIC diminished by about 16 folds for C. tropicalis. The potential antimicrobial activity of NLC-Flu-MTs and NLC-MTs nanoformulation towards different fungus strains promoted that all monoterpenes in addition to fluconazole reacted synergistically causing potential microbial growth inhibition (Supplementary information).
Figure 12.
Antifungal evaluation of the encapsulated NLC-Flu-MTs (1), NLC-MTs (2), positive control (c) and untreated blank (B) against Geotrichum candidum and Candida tropicalis.
Figure 13.
Antifungal evaluation of the encapsulated NLC-Flu-MTs (1), NLC-MTs (2), positive control (C) and untreated blank(B) agains Asp. niger and Mucor citcinelloid.
Figure 14.
Antifungal evaluation of the encapsulated NLC-Flu-MTs (1), NLC-MTs (2), positive control (c) and untreated blanks against C. albicans.
Conclusion
Carvacrol, geraniol, citronellal, nerolidol, and α-terpinene were chosen to be co-delivered with fluconazole to vicinity nanostructure lipid carrier due to their unique antifungal. The accumulative effect of NLC co-delivered MTs in addition to fluconazole was investigated against five pathogenic fungal strains. The six MTs successfully loaded with loading efficiency near to 99% and very good release profile. The synergistic effect of NLC-Flu-MTs nanoparticles showed wide inhibition zones all through most of the tested organisms with very promising minimal inhibitory concentration especially for the Candida tropicalis strain of 0.97 µg/ml with very interesting values with the other species. Novel chromatography approach was developed to estimate the abundance and the concentration of monoterpenes loaded and released.
Supplementary Information
Author contributions
Nadia Hanfy Metwally has generally supervised the work and has provides the conceptions, follow the data interpretations, original manuscript writing and reviewing process handling. Ibrahim M. El-Sherbiny has generally supervised also the work, provides the conceptions, follow data interpretations and original manuscript reviewing. Ibrahim Taha Radwan has performed the experimental work, carried out the needed analysis and data presentation and original manuscript writing.
Funding
Open access funding provided by The Science, Technology & Innovation Funding Authority (STDF) in cooperation with The Egyptian Knowledge Bank (EKB).
Data availability
The datasets used and/or analyzed during the current study available from the corresponding author on reasonable request.
Competing interests
The authors declare no competing interests.
Footnotes
Publisher's note
Springer Nature remains neutral with regard to jurisdictional claims in published maps and institutional affiliations.
Supplementary Information
The online version contains supplementary material available at 10.1038/s41598-024-63149-x.
References
- 1.Fernandes CM, Dasilva D, Haranahalli K, McCarthy JB, Mallamo J, Ojima I, Poeta MD. The future of antifungal drug therapy: Novel compounds and targets. Antmicrob. Agents Chemother. 2021;65:1719–1720. doi: 10.1128/AAC.01719-20. [DOI] [PMC free article] [PubMed] [Google Scholar]
- 2.Inanov M, Ciric A, Stojkovic D. Emerging antifungal targets and strategies. Int. J. Mol. Sci. 2022;23:2756. doi: 10.3390/ijms23052756. [DOI] [PMC free article] [PubMed] [Google Scholar]
- 3.Palmiori F, Koutsokera A, Bernasconi E, Tunier P, Garnier CV, Ubags N. Recent advances in fungal infections: From lung ecology to therapeutic strategies with a focus on Aspergillus spp. Front. Med. 2022;9:832510. doi: 10.3389/fmed.2022.832510. [DOI] [PMC free article] [PubMed] [Google Scholar]
- 4.Tumer SA, Butler G. The candida pathogenic species complex. Cold Spring Harb. Perspect. Med. 2014;4:019778. doi: 10.1101/cshperspect.a019778. [DOI] [PMC free article] [PubMed] [Google Scholar]
- 5.Sharma J, Rosiana S, Razzaq I, Shapiro SR. Linking cellular morphogenesis with antifungal treatment and subsceptibility in candida pathogens. Fungi (Basel) 2019;5:1–28. doi: 10.3390/jof5010017. [DOI] [PMC free article] [PubMed] [Google Scholar]
- 6.Nanjan MJ, Mohammed M, Kumar PRB, Chandrasekar MJN. Thiazolidinedi-ones as antidiabetic agents: A critical review. Bioorg. Chem. 2018;77:548–567. doi: 10.1016/j.bioorg.2018.02.009. [DOI] [PubMed] [Google Scholar]
- 7.Metwally NH, Radwan IT, El-Serwy WS, Mohamed MA. Design, synthesis, DNA assessment and molecular docking study of novel 2-(pyridin-2-ylimino)thiazolidin-4-one derivatives as potent antifungal agents. Bioorg. Chem. 2019;84:456–467. doi: 10.1016/j.bioorg.2018.11.050. [DOI] [PubMed] [Google Scholar]
- 8.Schoustra SE, Debets AJM, Rijs AJMM, Zhang J, Snelders E, Leendertse PC, Melchers WJG, Rietveld AG, Zwaan BJ, Verweij PE. Environmental hotspots for azole resistance selection of Aspergillus fumigatus, The Netherlands. Emerg. Infect. Dis. 2019;25:1347–1353. doi: 10.3201/eid2507.181625. [DOI] [PMC free article] [PubMed] [Google Scholar]
- 9.Jorgensen LN, Heick TM. Azole use in agriculture, horticulture, and wood preservation—Is it indispensable? Front. Cell. Infect. Microbiol. 2021;11:730297. doi: 10.3389/fcimb.2021.730297. [DOI] [PMC free article] [PubMed] [Google Scholar]
- 10.Radwan IT, Elwahy AH, Darweesh AF, Sharaky M, Bagato N, Khater HF, Salem ME. Design, synthesis, docking study, and anticancer evaluation of novel bis-thiazole derivatives linked to benzofuran or benzothiazole moieties as PI3k inhibitors and apoptosis inducers. J. Mol. Struct. 2022;1265:133454. doi: 10.1016/j.molstruc.2022.133454. [DOI] [Google Scholar]
- 11.Marzi M, Farjam M, Kazemmejad Z, Shiroudi A, Kouhpayeh A, Zarenezhad EA. Recent overview of 1,2,3-triazole-contaning hybrids as novel antifungal agents: Focusing on synthesis, mechanism of action, and structure activity relationship (SAR) J. Chem. 2022;50:7884316. [Google Scholar]
- 12.Hitchcock CA. Cytochrome P-450-dependent 14 alpha-sterol demethylase of Candida albicans and its interaction with azole antifungals. Biochem. Soc. Trans. 1991;19:782–787. doi: 10.1042/bst0190782. [DOI] [PubMed] [Google Scholar]
- 13.Horne TJ, Hollomon DW. Molecular mechanisms of azole resistance in fungi. FEMS Microbiol. Lett. 1997;149:141–149. doi: 10.1111/j.1574-6968.1997.tb10321.x. [DOI] [PubMed] [Google Scholar]
- 14.Heimark L, Shipkova P, Greene J, Munayyer H, Tomaine TT, Domenico BD, Hare R, Pramanik BN. Mechanism of azole antifungal activity as determined by liquid chromatographic/mass spectrometric monitoring of ergosterol biosynthesis. J. Mass Spectrom. 2002;37:265–269. doi: 10.1002/jms.280. [DOI] [PubMed] [Google Scholar]
- 15.Yao D, Chen J, Chen W, Li Z. Mechanisms of azole resistance in clinical isolates of Candida glabrata from two hospitals in China. Infect. Drug Resist. 2019;12:771–781. doi: 10.2147/IDR.S202058. [DOI] [PMC free article] [PubMed] [Google Scholar]
- 16.Gu W, Guo D, Zhang L, Xu D, Sun S. The synergistic effect of azoles and fluoxetine against resistant Candida albicans strains is attributed to attenuating fungal virulence. Antimicrob. Agents Chemother. 2016;60:6179–6188. doi: 10.1128/AAC.03046-15. [DOI] [PMC free article] [PubMed] [Google Scholar]
- 17.Copping VMS, Barelle CJ, Hube B, Gow NAR, Brown AJP, Odds FC. Exposure of Candida albicans to antifungal agents affects expression of SAP2 and SAP9 secreted proteinase genes. J. Antimicrob. Chemother. 2005;55:645–654. doi: 10.1093/jac/dki088. [DOI] [PubMed] [Google Scholar]
- 18.Martinez RCR, Franceschini SA, Patta MC, Quintana SM, Cardido RC, Ferreira JC, DeMartinis ECP, Reid G. Improved treatment of vulvovaginal candidiasis with fluconazole plus probiotic Lactobacillus rhamnosus GR-1 and Lactobacillus reuteri RC-14. Lett. Appl. Microbiol. 2009;48:269–274. doi: 10.1111/j.1472-765X.2008.02477.x. [DOI] [PubMed] [Google Scholar]
- 19.Sardella D, Gatt R, Valdramidis VP. Assessing the efficacy of zinc oxide nanoparticles against Penicillium expansum by automated turbidimetric analysis. Mycology. 2017;9:43–48. doi: 10.1080/21501203.2017.1369187. [DOI] [PMC free article] [PubMed] [Google Scholar]
- 20.Shi XY, Yang YP, Zhang Y, Li W, Wang JD, Huang WN, Fan YM. Molecular identification and antifungal susceptibility of 186 Candida isolates from vulvovaginal candidiasis in southern China. J. Med. Microbiol. 2015;64:390–393. doi: 10.1099/jmm.0.000024. [DOI] [PubMed] [Google Scholar]
- 21.Yano J, Sobel JD, Nyirjesy P, Sobel R, Willian VL, Yu Q, Noverr MC. Current patient perspectives of vulvovaginal candidiasis: Incidence, symptoms, management and post-treatment outcomes. BMC Womens Health. 2019;19:48. doi: 10.1186/s12905-019-0748-8. [DOI] [PMC free article] [PubMed] [Google Scholar]
- 22.Rad MM, Zafarghandi S, Abbasabadi B, Tavallaee M. The epidemiology of Candida species associated with vulvovaginal candidiasis in an Iranian patient population. Eur. J. Obstet. Gynecol. Reprod. Biol. 2011;155:199–203. doi: 10.1016/j.ejogrb.2010.11.022. [DOI] [PubMed] [Google Scholar]
- 23.Hosseini SS, Yadegari MH, Rajabibazl M, Ghaemi EA. Inhibitory effects of carvacrol on the expression of secreted aspartyl proteinases 1–3 in fluconazole-resistant Candida albicans isolates. Iran J. Microbiol. 2016;8:401–409. [PMC free article] [PubMed] [Google Scholar]
- 24.Paul S, Mohanram K, Kannan I. Antifungal activity of curcumin-silver nano-particles against fluconazole-resistant clinical isolates of Candida species. Ayu. 2018;39:182–186. doi: 10.4103/ayu.AYU_24_18. [DOI] [PMC free article] [PubMed] [Google Scholar]
- 25.Hosseini SS, Joshaghani H, Shokohi T, Ahmadi A, Mehrbakhsh Z. Antifungalactivity of ZnO nanoparticles and nystatin and downregulation of SAP1-3 genes expression in fluconazole-resistant candida albicans isolates from vulvovaginal candidiasis. Infect. Drug Resist. 2020;13:385–394. doi: 10.2147/IDR.S226154. [DOI] [PMC free article] [PubMed] [Google Scholar]
- 26.Ghosh M, Mandal S, Roy A, Chakrabarty S, Chakrabarti G, Pradhan SK. Enhanced antifungal activity of fluconazole conjugated with Cu–Ag–ZnO nanocomposite. Mater. Sci. Eng. C Mater. Biol. Appl. 2020;106:110160. doi: 10.1016/j.msec.2019.110160. [DOI] [PubMed] [Google Scholar]
- 27.Hamad KM, Mahmoud NN, Al-Dabash S, Al-Samad LA, Abdallah M, Al-Bakri AG. Fluconazole conjugated-gold nanorods as an antifungal nanomedicine with low cytotoxicity against human dermal fibroblasts. RSC Adv. 2020;10:25889–25897. doi: 10.1039/D0RA00297F. [DOI] [PMC free article] [PubMed] [Google Scholar]
- 28.Lo WH, Deng FS, Chang CJ, Lin CH. Synergistic antifungal activity of Chitosan with fluconazole against candida albicans, candida tropicalis, and fluconazole-resistant strains. Molecules. 2020;25:5114. doi: 10.3390/molecules25215114. [DOI] [PMC free article] [PubMed] [Google Scholar]
- 29.Abdellatif AAH, El-Telbany DFA, Zayed G, Al-Sawahli MM. Hydrogel containing PEG-coated fluconazole nanoparticles with enhanced solubility and antifungal activity. J. Pharm. Innov. 2018;14:112–122. doi: 10.1007/s12247-018-9335-z. [DOI] [Google Scholar]
- 30.Abbaszadeh S, Sharifzadeh A, Shokri H, Khosravi AR, Abbaszadeh A. Antifungal efficacy of thymol, carvacrol, eugenol and menthol as alternative agents to control the growth of food-relevant fungi. J. Mycol. Med. 2014;24:51–56. doi: 10.1016/j.mycmed.2014.01.063. [DOI] [PubMed] [Google Scholar]
- 31.Zhang J, Ma S, Du S, Chen S, Sun H. Antifungal activity of thymol and carvacrol against postharvest pathogens Botrytis cinerea. J. Food Sci. Technol. 2019;56:2611–2620. doi: 10.1007/s13197-019-03747-0. [DOI] [PMC free article] [PubMed] [Google Scholar]
- 32.Niu C, Wang C, Yang Y, Chen R, Zhang J, Chen H, Zhug Y, Li J, Cheng J, Xu K, Chu M, Ren C, Zhang C, Jia C. Carvacrol induces candida albicans apoptosis associated with Ca2+/calcineurin pathway. Front. Cell Infect. Microbiol. 2020;10:192. doi: 10.3389/fcimb.2020.00192. [DOI] [PMC free article] [PubMed] [Google Scholar]
- 33.Hsu CC, Lai WL, Chuang KC, Lee MH, Tsai YC. The inhibitory activity of linalool against the filamentous growth and biofilm formation in Candida albicans. Med. Mycol. 2013;51:1–10. doi: 10.3109/13693786.2012.743051. [DOI] [PubMed] [Google Scholar]
- 34.Lima MIO, Medeiros ACA, Silva KVS, Cardoso GN, Lima EO, Pereira FO. Investigation of the antifungal potential of linalool against clinical isolates of fluconazole resistant Trichophyton rubrum. J. Mycol. Med. 2017;27:195–202. doi: 10.1016/j.mycmed.2017.01.011. [DOI] [PubMed] [Google Scholar]
- 35.Silva KVS, Lima MIO, Cardoso GN, Santos AS, Silva GS, Pereira FO. Inhibitory effects of linalool on fungal pathogenicity of clinical isolates of microsporum canis and microsporum gypseum. Mycoses. 2017;60:387–393. doi: 10.1111/myc.12606. [DOI] [PubMed] [Google Scholar]
- 36.Pereira FO, Mendes JM, Lima IO, Mota KSL, Oliveira WA, Lima EO. Antifungal activity of geraniol and citronellol, two monoterpenes alcohols, against Trichophyton rubrum involves inhibition of ergosterol biosynthesis. Pharm Biol. 2015;53:228–234. doi: 10.3109/13880209.2014.913299. [DOI] [PubMed] [Google Scholar]
- 37.Li WR, Shi QS, Ouyang YS, Chen YB, Duan SS. Antifungal effects of citronella oil against Aspergillus niger ATCC 16404. Appl. Microbiol. Biotechnol. 2013;97:7483–7492. doi: 10.1007/s00253-012-4460-y. [DOI] [PubMed] [Google Scholar]
- 38.Vasquez LR, Mesia LR, Ceferino HDC, Mesia WR, Andrés FM, Díaz CE, Coloma AG. Antifungal and herbicidal potential of piper essential oils from the peruvian Amazonia. Plants. 2022;11:1793. doi: 10.3390/plants11141793. [DOI] [PMC free article] [PubMed] [Google Scholar]
- 39.Lockhart SR, Wagner D, Iqbal N, Pappas PG, Andes DR, Kauffman CA, Brumble LM, Hadley S, Walker R, Ito JI, Baddley JW, Chiller T, Park BJ. A comparison of in vitro susceptibility of Candida species from cases of invasive candidiasisin solid organ and stem cell transplant recipients: Transplant-associated infections surveillance network (TRANSNET), 2001 to 2006. J. Clin. Microbiol. 2011;49:2404–2410. doi: 10.1128/JCM.02474-10. [DOI] [PMC free article] [PubMed] [Google Scholar]
- 40.Bagtzoglou AD, Dwivedi P, Ioannidou E, Shaqman M, Hull D, Burleson J. Oral Candida infection and colonization in solid organ transplant recipients. Oral Microbiol. Immunol. 2009;24:249–254. doi: 10.1111/j.1399-302X.2009.00505.x. [DOI] [PMC free article] [PubMed] [Google Scholar]
- 41.Brilhante RSN, Paiva MAN, Sampaio CMS, Teixeira CEC, Branco DSCMC, Leite JJG, Moreira CA, Silva LP, Cordeiro RA, Monteiro AJ, Sidrim JJC, Rocha MFG. Yeasts from Macrobrachium amazonicum: A focus on antifungal susceptibility and virulence factors of Candida spp. FEMS Microbiol. Ecol. 2011;76:268–277. doi: 10.1111/j.1574-6941.2011.01050.x. [DOI] [PubMed] [Google Scholar]
- 42.Brito EHS, Fontenelle ROS, Brilhante RSN, Cordeiro RA, Monteiro AJ, Sidrim JJC, Rocha MFG. The anatomical distribution and antimicrobial susceptibility of yeast species isolated from healthy dogs. Vet. J. 2009;182:320–326. doi: 10.1016/j.tvjl.2008.07.001. [DOI] [PubMed] [Google Scholar]
- 43.Sidrim JJC, Branco DSCMC, Brilhante RSN, Soares GDP, Cordeiro RA, Monteiro AJ. Rocha Candida species isolated from the gastrointestinal tract of cockatiels (Nymphicus hollandicus): In vitro antifungal susceptibility profi le and phospholipase activity. Vet. Microbiol. 2010;145:324–328. doi: 10.1016/j.vetmic.2010.04.006. [DOI] [PubMed] [Google Scholar]
- 44.Ingroff AE. Novel antifungal agents, targets or therapeutic strategies for the treatment of invasive fungal diseases: A review of the literature (2005–2009) Rev. Iberoam. Micol. 2009;26:15–22. doi: 10.1016/S1130-1406(09)70004-X. [DOI] [PubMed] [Google Scholar]
- 45.Vyas SP, Gupta S. Optimizing efficacy of amphotericin B through modification. Intern. J. Nanomed. 2006;40:417–432. doi: 10.2147/nano.2006.1.4.417. [DOI] [PMC free article] [PubMed] [Google Scholar]
- 46.Nicholls S, MacCallum DM, Kaffarnik FA, Selway L, Peck SC, Brown AJ. Activation of the heat shock transcription factor Hsf1 is essential for the full virulence of the fungal pathogen Candida albicans. Fungal Genet. Biol. 2011;48:297–305. doi: 10.1016/j.fgb.2010.08.010. [DOI] [PMC free article] [PubMed] [Google Scholar]
- 47.Rintala H, Pitkäranta M, Täubel M. Microbial communities associated with house dust. Adv. Appl. Microbiol. 2012;78:75–120. doi: 10.1016/B978-0-12-394805-2.00004-X. [DOI] [PubMed] [Google Scholar]
- 48.Li X, Zhang T, Wang S. Aerosolization of Aspergillus niger spores from colonies on different positions of a circular tube. E3S Web Conf. 2019;111:e02030. doi: 10.1051/e3sconf/201911102030. [DOI] [Google Scholar]
- 49.White JK, Nielsen JL, Madsen AM. Potential respiratory deposition and species composition of airborne culturable, viable, and non-viable fungi during occupancy in a pig farm. Atmosphere (Basel) 2020;11:639. doi: 10.3390/atmos11060639. [DOI] [Google Scholar]
- 50.Barac A, Ong DSY, Jovancevic L, Peric A, Surda P, Spiric VT, Rubino S. Fungi-induced upper and lower respiratory tract allergic diseases: One entity. Front. Microbiol. 2018;9:583. doi: 10.3389/fmicb.2018.00583. [DOI] [PMC free article] [PubMed] [Google Scholar]
- 51.Person AK, Chudgar SM, Norton BL, Tong BC, Stout JE. Aspergillus niger: An unusual cause of invasive pulmonary aspergillosis. J. Med. Microbiol. 2010;59:834–838. doi: 10.1099/jmm.0.018309-0. [DOI] [PMC free article] [PubMed] [Google Scholar]
- 52.Jenks J, Hoenigl M. Treatment of aspergillosis. J. Fungi. 2018;4:98. doi: 10.3390/jof4030098. [DOI] [PMC free article] [PubMed] [Google Scholar]
- 53.Reischies F, Hoenigl M. The role of surgical debridement in different clinical manifestations of invasive aspergillosis. Mycoses. 2014;57(2014):1–14. doi: 10.1111/myc.12224. [DOI] [PubMed] [Google Scholar]
- 54.Snelders E, Veld RAGHI, Rijs AJMM, Kema GHJ, Melchers WJG, Verweij PE. Possible environmental origin of resistance of Aspergillus fumigatus to medical triazoles. Appl. Environ. Microbiol. 2009;75:4053–4057. doi: 10.1128/AEM.00231-09. [DOI] [PMC free article] [PubMed] [Google Scholar]
- 55.Azevedo MM, Ramos IF, Cruz LC, Vaz CP, Rodrigues AG. Genesis of azole antifungal resistance from agriculture to clinical settings. J. Agric. Food Chem. 2015;63:7463–7468. doi: 10.1021/acs.jafc.5b02728. [DOI] [PubMed] [Google Scholar]
- 56.Narbona MT, Guinea J, Alarcon JM, Munoz P, Gadea I, Bouza E. Impact of zygomycosis on microbiology workload: A survey study in Spain. J. Clin. Microbiol. 2007;45:2051–2053. doi: 10.1128/JCM.02473-06. [DOI] [PMC free article] [PubMed] [Google Scholar]
- 57.Kontoyiannis DP, Lewis RE. How I treat mucormycosis. Blood. 2011;118:1216–1224. doi: 10.1182/blood-2011-03-316430. [DOI] [PMC free article] [PubMed] [Google Scholar]
- 58.Katragkou A, Walsh TJ, Roilides E. Why is mucormycosis more difficult to cure than more common mycoses? Clin. Microbiol. Infect. 2014;20:74–81. doi: 10.1111/1469-0691.12466. [DOI] [PubMed] [Google Scholar]
- 59.Farghali MA, Selim AM, Khater HF, Bagato N, Alharbi W, Alharbi KH, Radwan TI. Optimized adsorption and effective disposal of Congo red dye from wastewater: Hydrothermal fabrication of MgAl-LDH nanohydrotalcite-like materials. Arab. J. Chem. 2022;15:104171. doi: 10.1016/j.arabjc.2022.104171. [DOI] [Google Scholar]
- 60.Radwan IT, Baz MM, Khater H, Alkhaibari AM, Selim AM. Mg-LDH nanoclays intercalated fennel and green tea active ingredient: Field and laboratory evaluation of insecticidal activities against culex pipiens and their non-target organisms. Molecules. 2022;27:2424. doi: 10.3390/molecules27082424. [DOI] [PMC free article] [PubMed] [Google Scholar]
- 61.Metwally NH, Deeb EA. Synthesis, anticancer assessment on human breast, liver and colon carcinoma cell lines and molecular modeling study using novel pyrazolo[4,3-c]pyridine derivatives. Bioorg. Chem. 2018;77:204–208. doi: 10.1016/j.bioorg.2017.12.032. [DOI] [PubMed] [Google Scholar]
- 62.Metwally NH, Badawy MA, Okpy DS. Green synthesis of some new thiopyrano[2,3-d][1,3]thiazoles using lemon juice and their antibacterial activity. Synth. Comm. 2018;48:2496–2509. doi: 10.1080/00397911.2018.1495234. [DOI] [Google Scholar]
- 63.Metwally NH, Mohamed MS, Ragb EA. Design, synthesis, anticancer evaluation, molecular docking and cell cycle analysis of 3-methyl-4,7-dihydropyrazolo [1,5-a]pyrimidine derivatives as potent histone lysine demethylases (KDM) inhibitors and apoptosis inducers. Bioorg. Chem. 2019;88:102929. doi: 10.1016/j.bioorg.2019.102929. [DOI] [PubMed] [Google Scholar]
- 64.Metwally NH, Saad GR, Abdwahab EA. Grafting of multiwalled carbon nanotubes with pyrazole derivatives: Characterization, antimicrobial activity and molecular docking study. Inter. J. Nanomed. 2019;14:6645–6659. doi: 10.2147/IJN.S182699. [DOI] [PMC free article] [PubMed] [Google Scholar]
- 65.Metwally NH, Abdallah SO, Mohsen MAA. Design, green one-pot synthesis and molecular docking study of novel N, N-bis (cyanoacetyl) hydrazines and bis-coumarins as effective inhibitors of DNA gyrase and topoisomerase IV. Bioorg. Chem. 2020;97:103672. doi: 10.1016/j.bioorg.2020.103672. [DOI] [PubMed] [Google Scholar]
- 66.Metwally NH, Ragab EA, Mohammed MS. Synthesis of some novel N5-sulfonylated and N1-alkyated pyrazole derivatives and their antimicrobial activity in conjunction with molecular docking study. J. Heterocyclic Chem. 2020;57:1678–1713. doi: 10.1002/jhet.3895. [DOI] [Google Scholar]
- 67.Metwally NH, Mohamed MS, Deeb EA. Synthesis, anticancer evaluation, CDK2 inhibition, and apoptotic activity assessment with molecular docking modeling of new class of pyrazolo[1,5-a]pyrimidines. Res. Chem. Intermed. 2021;47:5027–5060. doi: 10.1007/s11164-021-04564-x. [DOI] [Google Scholar]
- 68.Metwally NH, Koraa TH, Sand SMH. Green one-pot synthesis and in vitro antimicrobial screening of pyrano[2,3-d]pyrazoles, 4H-chromenes and pyrazolo[1,5-a]pyrimidines using biocatalyzed pepsin. Synth. Comm. 2022;52:1139–1154. doi: 10.1080/00397911.2022.2074301. [DOI] [Google Scholar]
- 69.Metwally NH, Badawy MA, Okpy DS. Synthesis, biological evaluation of novel thiopyrano[2,3-d]thiazole hybrids as potential nonsulfonamide human carbonic anhydrase IX and XII inhibitors: Design, synthesis and biochemical studies. J. Mol. Struct. 2022;1258:132648. doi: 10.1016/j.molstruc.2022.132648. [DOI] [PMC free article] [PubMed] [Google Scholar]
- 70.Metwally NH, El-Dosoky EA. Novel thiopyrano[2,3-d]thiazole-pyrazole hybrids as potential nonsulfonamide human carbonic anhydrase IX and XII inhibitors: Design, synthesis, and biochemical studies. ACS Omega. 2023;8:5571–5592. doi: 10.1021/acsomega.2c06954. [DOI] [PMC free article] [PubMed] [Google Scholar]
- 71.Radwan IT, Baz MM, Khater H, Selim AM. Nanostructured lipid carriers (NLC) for biologically active green tea and fennel natural oils delivery: Larvicidal and adulticidal activities against culex pippins. Molecules. 2022;27:1939. doi: 10.3390/molecules27061939. [DOI] [PMC free article] [PubMed] [Google Scholar]
- 72.Artigas AM, Pérez LY, Belloso MO. Curcumin-loaded nanoemulsions stability as affected by the nature and concentration of surfactant. Food Chem. 2018;266:466–474. doi: 10.1016/j.foodchem.2018.06.043. [DOI] [PubMed] [Google Scholar]
- 73.Kamel KM, Khalil IA, Rateb ME, Elgendy H, Elhawary S. Chitosan-coated cinnamon/oregano-loaded solid lipid nanoparticles to augment 5-fluorouracil cytotoxicity for colorectal cancer: extract standardization, nanoparticle optimization, and cytotoxicity evaluation. J. Agric. Food Chem. 2017;65:7966–7981. doi: 10.1021/acs.jafc.7b03093. [DOI] [PubMed] [Google Scholar]
- 74.Blokhina S, Ol'khovich M, Sharapova A, Perlovich G. Experimental investigation of fluconazole: Equilibrium solubility and sublimation. J. Chem. Thermody. 2020;151:106243. doi: 10.1016/j.jct.2020.106243. [DOI] [Google Scholar]
- 75.Cabeza RL, Kah M, Grillo R, Bílkováa Z, Hofman J. Is centrifugal ultrafiltration a robust method for determining encapsulation efficiency of pesticide nanoformulations? Nanoscale. 2021;13:5410–5418. doi: 10.1039/D0NR08693B. [DOI] [PubMed] [Google Scholar]
- 76.Magaldia S, Essayaga SM, Caprilesa CH, Pereza C, Colella MT, Olaizolaa C, Ontiverosb Y. Well diffusion for antifungal susceptibility testing. Inter. J. Infect. Dise. 2004;8:39–45. doi: 10.1016/j.ijid.2003.03.002. [DOI] [PubMed] [Google Scholar]
- 77.Ingroff EA, Canton E, Fothergill A, Ghannoum M, Johnson E, Joned RN, Zeichner LO, Schell W, Gibbs DL, Wang A, Turnidge J. Quality control guidelines for amphotericin B, itraconazole, posaconazole and voriconazole disk diffusion susceptibility tests with non-supplemented Mueller-Hinton agar (M51-A document) for nondermatophyte filamentous fungi. J. Clin. Microbiol. 2011;49:2568–2571. doi: 10.1128/JCM.00393-11. [DOI] [PMC free article] [PubMed] [Google Scholar]
- 78.Wiegand I, Hilpart K, Hancocpa REW. Agar and broth dilution methods to determine the nminimal inhibitory concentration (MIC) of antimicrobial substances. Nat. Protocols. 2008;3:163–175. doi: 10.1038/nprot.2007.521. [DOI] [PubMed] [Google Scholar]
- 79.Narawi MN, Chiu HI, Yong YK, Zain NNM, Ramachandran MR, Tham CL, Samsurrijal SF, Lim V. Biocompatible nutmeg oil-loaded nanoemulsion as phyto-repellent. Front. Pharmacol. 2020;11:214. doi: 10.3389/fphar.2020.00214. [DOI] [PMC free article] [PubMed] [Google Scholar]
- 80.Yu M, Yuan W, Li D, Schwendeman A, Schwendeman SP. Predicting drug release kinetics from nanocarriers inside dialysis bags. J. Control Release. 2019;10:23–30. doi: 10.1016/j.jconrel.2019.09.016. [DOI] [PubMed] [Google Scholar]
- 81.Apalli VK, Kaul V, Gorantla S, Waghule T, Dubey SK, Pandey MM, Singhvi G. UV Spectrophotometric method for characterization of curcumin loaded nanostructured lipid nanocarriers in simulated conditions: Method development, in-vitro and ex-vivo applications in topical delivery. Spectrochimica Acta Part A Mol. Biomol. Spectrosc. 2020;224:117392. doi: 10.1016/j.saa.2019.117392. [DOI] [PubMed] [Google Scholar]
- 82.Pedersen DS, Capone DL, Skouroumounis GK, Pollnitz AP, Sefton MA. Quantitative analysis of geraniol, nerol, linalool, and α-terpineol in wine. Anal. Bioanal. Chem. 2003;375:517–522. doi: 10.1007/s00216-002-1716-x. [DOI] [PubMed] [Google Scholar]
Associated Data
This section collects any data citations, data availability statements, or supplementary materials included in this article.
Supplementary Materials
Data Availability Statement
The datasets used and/or analyzed during the current study available from the corresponding author on reasonable request.









